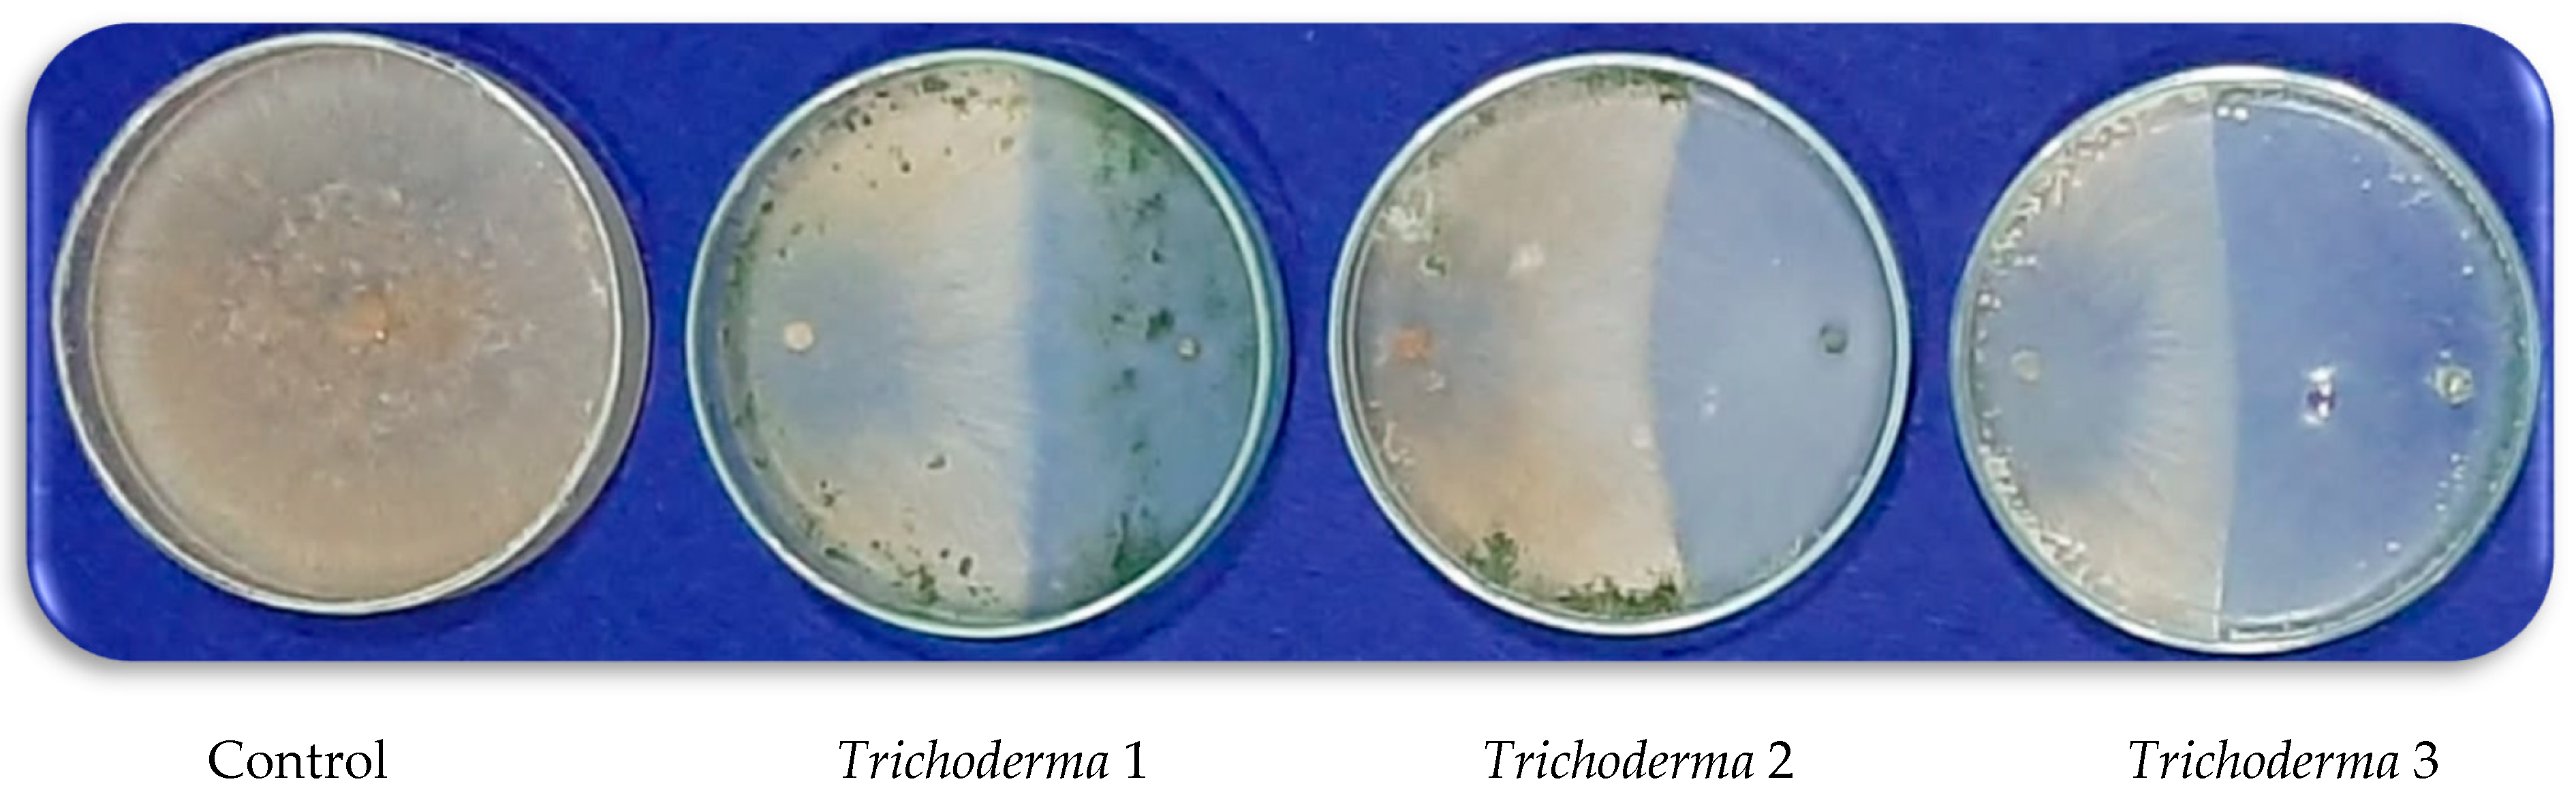
Agronomy 12 03186 g003
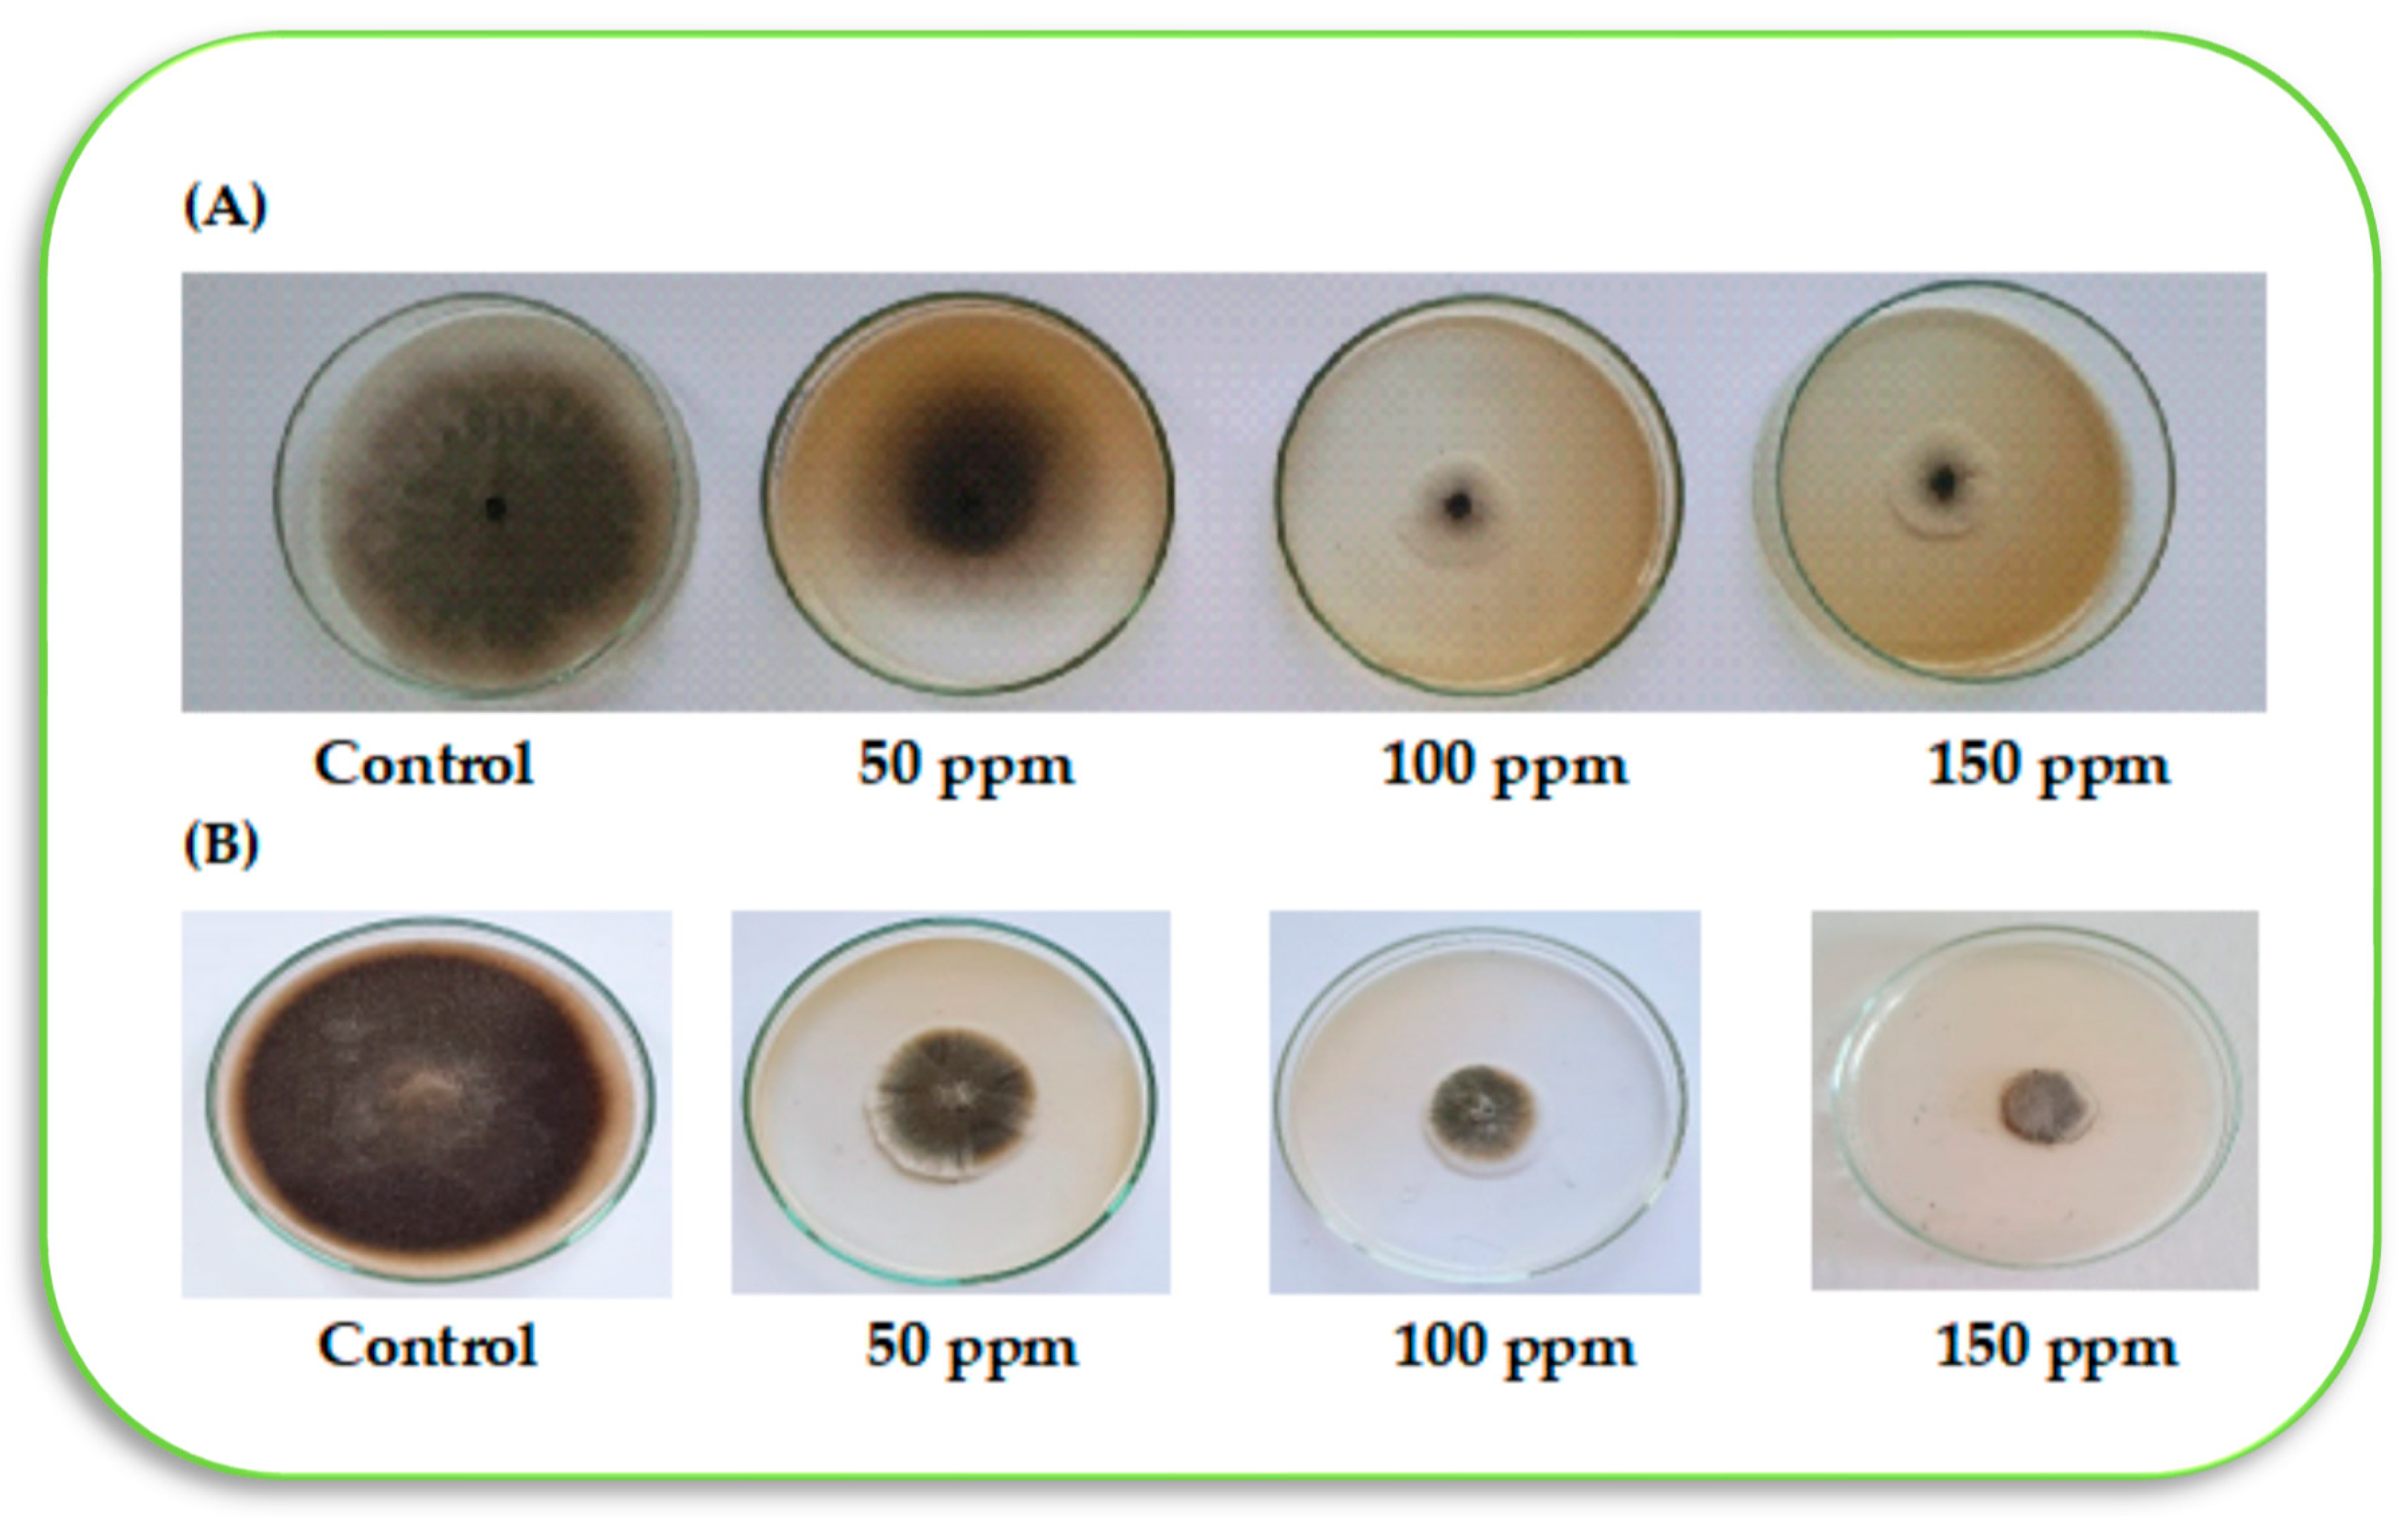
Agronomy 12 03186 g010

1. Introduction
Tomato is the second-global consumed vegetable crop after the potato, which can be consumed as fresh or processed via food processing [
1,
2]. The production of tomato crops may face several obstacles, especially biotic stresses, which result from many known diseases caused by bacteria, fungi, fungi-like viruses, and nematodes [
2]. Various pathogens as soil-borne fungal diseases include different species such as
Fusarium,
Rhizoctonia,
Pythium, and
Verticillium, which are responsible for wilting, and damping-off tomato seedlings [
3]. The fungal pathogens can cause some common diseases in tomato, such as
Rhizoctonia solani and
Fusarium oxysporum f. sp.
lycopersici. These diseases lead to economic losses due to reducing the yield of tomatoes [
4]. These losses are dangerous during all tomato growing stages, especially the seedling period. Soil-borne diseases could be managed by applying several chemical compounds like paclobutrazol [
5], organic compounds like biochar [
6], or biological agents like
Trichoderma spp. [
2].
Paclobutrazol (PBZ) is a plant growth regulator which can modify plant hormonal balance by increasing cytokinin levels and inhibiting gibberellin synthesis [
7]. This regulation could reduce stem elongation, enhance crop tolerance/resistance to biotic/abiotic stress and then increase crop yield [
5].
Rhizoctonia solani is one of the most damaging and destructive pathogens of tomatoes and various crops, which was confirmed in many areas worldwide [
2,
8]. Due to the extensive use of fungicides and/or chemical control agents, numerous risks and environmental problems have resulted in human health and agroecosystem [
3]. Many sustainable methods can control
R. solani on tomatoes, including biological control agents, using nanomaterials like nano-chitosan [
9], volatile organic compounds [
10], or plant extracts [
2], as eco-friendly and effective tools in managing this pathogen. The most common biocontrol species for
R. solani in tomato include
Trichoderma spp. and
Bacillus subtilis, by inhibiting the growth of pathogens or progress through different strategies such as the direct intact or by producing cell lysis enzymes or siderophores [
2,
3].
Trichoderma is an important fungal genus that commonly uses as a biocontrol agent [
11]; because of its great potential to inhibit the growth of several phytopathogens [
12,
13,
14]. As an important strain,
Trichoderma harzianum is widely used in bio-controlling a variety of phytopathogens like
Rhizoctonia solani. Many species of
Trichoderma have an excellent ability to produce several metabolites to biocontrol phytopathogens [
15,
16] through different mechanisms, including anti-biotism, competition, and mycoparasitism [
14]. The suggested mechanism of
Trichoderma on suppressing
R. solani may depend on the crop and
Trichoderma species such as
T. asperellum TV190 [
17],
T. virens ZT05 [
18], and
T. asperelloides Ta41 [
2]. Interestingly, Bayoumi et al. [
19] indicated that the application of sulfur promoted the growth of
T. harzianum and increased significantly its ability to decrease the disease severity of
Alternaria porri, which causes purple blotch of onion plants.
Therefore, previous studies have confirmed the effectiveness of T. harzianum in controlling R. solani, but this study, as a first report, approved the combined applied both T. harzianum and PBZ on this pathogen. To the best of our knowledge, no study that has explored the promotive relationship between PBZ and T. harzianum in managing the growth of tomato seedlings under R. solani stress.
2. Materials and Methods
2.1. Isolation and Identification of the Pathogens
Five pathogens were collected from tomato seedlings grown under commercial nurseries in Kafr El-Sheikh governorate, Egypt (Latitude 31°06′25.20″ N Longitude: 30°56′26.99″ E). These pathogens included
Pythium spp.,
Macrophomina phaseolina,
Fusarium spp.,
Alternaria spp., and
Rhizoctonia solani. These pathogens represent the most dominant pathogens in the region of Kafr El-Sheikh, causing root rot in tomato seedlings during the seedlings’ growth period under the nursery conditions. In brief, tomato seedlings infected with root rot, showing typical symptoms, were collected from different tomato nurseries. Diseased roots were cut into pieces of 5 mm, sterilized on their surface using sodium hypochlorite solution (5%) for two minutes, and then washed 4 times with sterilized distilled water. Two layers of sterilized filter papers were used to dry samples and then transferred into potato dextrose agar (PDA) medium at 28 °C for 24–48 h in 9 cm Petri dishes, according to Dhingra and Sinclair [
20]. The developed fungal culture was purified using the hyphal tip isolation technique for all pathogens. These pathogens were microscopically examined and identified as
R. solani,
Fusarium spp.,
Pythium spp.,
M. phaseolina, and
Alternaria spp. based on their morphological features and microscopic parameters as described by Leslie and Summerell [
21].
2.2. Pathogenicity Test and Its Assessments
The purified pathogens were investigated for their pathogenicity on tomato (El Otts (E448), F1 hybrid, which was obtained from Syngenta Company (Basel, Switzerland) in seedling trays under greenhouse conditions. Temporarily, 7-day-old cultures of all pathogens (
Fusarium spp.,
Pythium spp.,
R. solani,
M. phaseolina, and
Alternaria spp.) were grown on a barely-sandy medium. Throughout the preparation of the media mixture (coco peat: vermiculite), the grains barely infested by pathogens were mixed (1:1
w/
w) separately with the media and filled the trays directly. The infested trays were watered when needed and left for one week to enhance the establishment of the growth of different pathogens in the media. Tomato seeds were surface sterilized with 1% sodium hypochlorite solution for two minutes, then rinsed in sterile distilled water (SDW). Experiments were arranged in three replicates; each replicate was three trays per pathogen beside the negative control, which used trays without any pathogen (non-infested). Styrofoam trays (209 cells) were used in this experiment. Pre- and post-emergence damping-off for tomato seedlings were assessed after 15 and 30 days from the sowing date, respectively, according to Raju and Naik [
22]. The pre- and post-emergence damping-off was calculated according to the following equation:
Subsequently, the most virulence pathogen was confirmed as R. solani based on their characteristics and pathogenicity symptoms of root rot disease on tomato seedlings. This pathogen was identified as R. solani in the Agricultural Research Center (ARC), Plant Pathology Research Institute, Mycology and Disease Survey Research Department in Giza, Egypt.
2.3. Screening of Trichoderma Isolates against R. solani
After collecting some soil samples from the rhizosphere, obtained from healthy roots of tomato plants, three isolates from Trichoderma spp. were isolated from different tomato fields in Kafr El-Sheikh governorate, Egypt. Using a 5 mm diameter disc of pathogen (R. solani) potato dextrose agar (PDA) plates were incubated from 5 days old culture. Opposite the pathogen, a disc of 7-day-old culture of each different antagonistic fungal isolate was placed at a constant distance away from the opposite edge of the Petri dishes. Five Petri dishes were used for each antagonist. Inoculated plates were incubated at 28 ± 2 °C for five days. When mycelial growth covered the entire medium surface in the untreated control treatment (5 days old), plates were then examined, and linear growth was determined.
The isolation of
Trichoderma isolates was performed using rhizosphere soil samples, which were collected from healthy roots of tomato growing in some areas of Kafr El-Sheikh Governorate (i.e., Sedi Salem, Baltim, and Qaleen), Egypt. Soil samples were collected, air dried and grounded. A stock solution of the sample is prepared by dissolving 10 g of grounded soil into 90 mL of sterilized distilled water in a conical flask (250 mL and carefully shaken for 10 min). The next step was making serial dilutions of samples, which were prepared as 10
−1, 10
−2… 10
−5 dilution series up to 10
8 CFU/mL [
23]. One mL of each of the prepared dilutions was spread evenly on a suitable medium on the surfaces of Petri dishes containing PDA media using a sterilized Driglasky glass triangle. Plates were incubated at 28 ± 2 °C for a sufficient period and examined daily for the fungal growth.
2.4. Antifungal Activity of Paclobutrazol
Four concentrations of paclobutrazol (PBZ; Super coltar, 25%) from Shoura Company for Chemicals, Giza, Egypt, were used (i.e., 0, 50, 100, and 150 mg L
−1). The antifungal activity of PBZ was evaluated in vitro using the agar diffusion technique [
24]. Briefly, the selected doses of PBZ were prepared through the proper mixture of each concentrate with 100 mL of the PDA medium using sterilized Petri dishes. Subsequently, inoculation of the pre-prepared Petri dishes, which contained a 5-mm diameter mycelial plug of a freshly prepared
R. solani culture. After 5 days post-inoculation (dpi), plates were incubated at 28 ± 2 °C, and fungal growth was recorded. Additionally, selected doses of PBZ for the antifungal activity (i.e., 0, 50, 100, and 150 mg L
−1) were assessed in vitro against 3 isolates of
Trichoderma. The complete experiment was repeated twice using 5 biological replicates for each selected dose. The reduction rate in growth (%) has been determined using the following equation according to Ferreira et al. [
25]:
where “T” is mycelium growth, and “C” is mycelium growth in the negative control plate in each treatment.
One isolate of Trichoderma spp. out of the three isolates selected was unaffected by the PBZ application. This isolate (Trichoderma 1) was used to study the antifungal activity against the pathogen of R. solani on PDA treated with applied PBZ treatments. Trichoderma 1 was identified as T. harzianum in ARC, Plant Pathology Research Institute, and the Mycology and Disease Survey Research Department in Giza, Egypt, based on their morphological and microscopical features. The examination with a scanning electron microscope (SEM, JEOL JSM 6510 Iv, Tokyo, Japan) has been carried out at the Nanotechnology Institute, Kafrelsheikh University, to assess the impact of PBZ application on the growth changes of both R. solani and T. harzianum after 5 days from inoculation on PDA media.
2.5. Plant Materials and Growth Conditions
The work of the two seasons of 2021 and 2022 was carried out in the nursery of the Faculty of Agriculture, Kafrelsheikh University. The main target of this study was to control the disease of root rot caused by R. solani and to improve tomato seedlings’ quality using combined and/or separated applied PBZ and Trichoderma under the nursery conditions. The root rot-susceptible tomato hybrid (El Otts, E448) was used in all experiments. Using the trays (209 cells), seeds were sown in the nursery of the protected cultivation center, Kafrelsheikh University, Faculty of Agriculture in Egypt.
The experiments were conducted in Styrofoam trays of seedlings commonly used in nurseries. Seedling trays were placed on stands at a height of 90 cm from the surface of the ground in a climate-controlled greenhouse (28 ± 2 °C, 77 ± 4% RH, and 12:12 h L/D photocycle) placed at the Faculty of Agriculture, Kafrelsheikh University, Kafr El-Sheikh, Egypt (31°06′42″ N, 030°56′45″ E). We used the mixture of coco peat: vermiculite (1:1
v/
v) to fill Styrofoam trays 209 cells as growing media, which is brown, like soil, it is light and spongy and crumbles into tiny splinters. Seedling trays were irrigated manually daily using a hose with a sprinkler nozzle, and all trays took the same water amount, to maintain the medium at the field capacity. During the seedling’s growth, it was fertilized twice weekly after the emergence by a soluble compound fertilizer containing 350 N, 350 P
2O
5, 350 K
2O (mg L
−1). Compound fertilizer solution was applied with a sprinkler system used in the irrigation. Treatments were arranged in 4 replicates; each replicate was 3 trays per treatment. While preparing the substrate mixture (coco peat: vermiculite), the following treatments were applied (
Table 1).
Healthy seedlings treatment (uninfected with R. solani) as a negative control. Control as a positive control (infected with R. solani), which were selected as 7-day-old cultures of the pathogen (R. solani) and grown on a barely-sandy medium. During the preparation of growing media (coco peat: vermiculite), the grains barely infested by R. solani (1:1 w/w) were mixed with the media, and the trays were filled directly. The infested trays were watered when needed and left for one week to enhance the establishment of the pathogen growth in the media. Trichoderma application (infected with R. solani), as the result of antifungal activities of PBZ on the different isolates of Trichoderma 1, we used T. harzianum, which was grown on a medium of potato dextrose broth and incubated on rotary shaker using 250 rpm at 25 ± 2 °C for 10 days. Spore suspensions of T. harzianum were counted and adjusted at 106 spore mL−1 by a hemocytometer slide. PBZ application (infected with R. solani), as the result of different concentrations used, we selected 100 mg L−1 for this experiment. The combined application between T. harzianum and PBZ (100 mg L−1) to infected plants with R. solani. Fungicide application that infected with the studied pathogen (R. solani), the fungicide (i.e., Rizolex 50% WP, manufactured by Sumitomo Chemical Co., Tokyo, Japan) at the rate of the recommended dose for nursery media; 2 g L−1 media, was applied.
All treatments were conducted before seeds were sowed directly by drenching in the seedling trays. Tomato seeds were surface sterilized with 1% sodium hypochlorite solution for two minutes, then rinsed in SDW. Experiments used Styrofoam trays 209 cells arranged in four replicates; each replicate was three trays per each treatment besides the negative control, which used trays without any infection (non-infested). Seedling trays were sown manually, one seed per cell, and covered with the above-mentioned media. After sowing, trays were put under greenhouse conditions, and the temperature ranged from 28 ± 2 °C during the experimentation for 30 days.
2.6. Disease Assessments
The damping-off percentages of tomato seedlings were assessed after sowing by 15 and 30 days, respectively, according to Chandler and Santelman [
26]. Also, at 30 days-old seedlings were uprooted carefully from the trays and washed with tap water; the disease severity was assessed using a 5-rating scale (1 = healthy, 2 = main root tip necrotic, 3 = main root tip soft and decayed, 4 = defunct seedling, germinated seed with decayed radical and 5 = defunct seed, ungerminated seed) as described by Altier and Thies [
27]. Disease severity % was recorded by the equation:
2.7. Vegetative Growth Assessments
Different parameters of vegetative growth of seedlings were measured for all treatments and control in both seasons after 30 d from the sowing date. The measured growing parameters included stem diameter (mm), seedling height, which was measured from the medium surface to the shoot apex (cm), fresh and dry weight of seedling (g/seedling), and dry mass was recorded after drying at 65 °C for 48 h. The replication was four replicates with five plants in each studied season.
2.8. Chlorophyll Content and Its Florescence
The content of chlorophyll was measured in seedlings using the method of Nagata and Yamashita [
28] by spectrophotometer at a wavelength of 645 and 663 nm and calculating by substituting the reading in the following Equations:
The extraction of chlorophyll was done by organic solvent
N,
N-Dimethyl Formamide, 1 g from fresh leaves put in 5 mL
N,
N-Dimethyl Formamide and after 24 h (dark conditions), measured by Spectrophotometer at two wavelengths, 663 and 645 nm for each replicate and after that calculate both of Chlorophyll a and b (the unit is mg g
−1 FW). The maximum efficiency of the photosystem (PSII) as (Fv/Fm) was determined by a portable Optic-Science OS-30p + Fluorometer (Opti-Sciences, Inc., Hudson, NH, USA) according to Maxwell and Johnson [
29].
2.9. Antioxidant Enzymes and Antioxidative Capacity
For enzyme activity, 0.5 g plant tissues were standardized in 3 mL of 0.05 M Tris buffer (pH 7.8), containing 0.001 M EDTA–Na
2 and 7.5% Polyvinylpyrrolidone at 0–4 °C. The homogenates were measured colorimetrically using a spectrophotometer (Shimadzu, Kyoto, Japan). Catalase (CAT) enzyme was determined according to Aebi [
30]. The activity peroxidase (POX) was evaluated according to Rathmell and Sequeira [
31]. Polyphenol oxidase (PPO) activity was determined according to the method described by Malik and Singh [
32]. The antioxidative capacity of proteins was determined by the DPPH method according to Binsan et al. [
33] at 517 nm using a spectrophotometer (Helios Gamma; Thermo Fisher Scientific, Waltham, MA, USA).
2.10. Electrolyte Leakage
According to Lutts et al. [
34], electrolyte leakage of tomato seedlings was determined by an EC or electrical conductivity meter (Fistreem Jenway Bench Top EC meter, Model 3510, Medica Scientific Company, Cheshire, UK). All vegetative growth parameters, chlorophyll fluorescence, chlorophyll content, antioxidant enzymes, and electrolyte leakage were assessed after 30 days from seeds sowing in the seedling trays in the 2021 and 2022 seasons.
2.11. Statistical Analysis
Completely randomized design (CRD) was used in all experiments during both seasons. All the obtained data were arranged and analyzed using Duncan’s Multiple Range Test for comparing between means of different treatments. According to the Co-STAT computer software package (version 6.451), all statistical analyses were performed, and the means were compared according to Duncan’s multiple range test [
35]. Calculating the standard error using Excel version 2016 with Windows 10 Pro.
4. Discussion
Tomato plants are exposed to many pathogens and pests during their production in an open field and/or under greenhouse conditions, especially at the seedlings’ growth stage. Abiotic and biotic stresses are the main constraints that threaten the growth and productivity of tomato plants. In the current study, the root rot disease caused by
R. solani is the studied biotic stress. Chemical control (i.e., PBZ) and/or biological control (
Trichoderma harzianum) were applied to manage the infected tomato seedlings with
R. solani. Therefore, this study was carried out to answer the following questions what is the expected role of applied PBZ alone under different doses in managing the growth of infected tomato seedlings with
R. solani? To what extent can applied PBZ improve the resistance of infected tomato seedlings with
R. solani when co-apply with the bioagent of
Trichoderma? Is the suggested integrated chemical/biological control effectively managing the root rot disease caused by
R. solani? Based on the previous study, PBZ was selected in the current study as an effective agent in ameliorating the biotic stress, which caused by
Alternaria solani (the early blight disease) under greenhouse conditions [
1]. (
Figure 9).
So, the present study was designed to determine the effect of applied higher doses of PBZ (up to 150 mg L
−1) in enhancing the resistance of tomato seedlings against the disease caused by
R. solani. With respect to the first research question, it was found that applied PBZ up to 150 mg L
−1 inhibited the growth of
R. solani mycelium recording the highest reduction rate (78.6%). The reason may back to the ability of PBZ in inducing the resistance of tomato seedlings to root rot disease (i.e., infected with
R. solani) by increasing the leaf greenness and making the root system stronger [
1]. The most interesting finding was that applied PBZ up to 150 mg L
−1 did not inhibit the growth of
Trichoderma (species no. 1, namely
T. harzianum), where the reduction was 0.0%, and the mycelium growth was complete at 9.0 cm (
Table 3). This is a very important result, which was the starting point in our study to use the integrative application of a chemical (PBZ) and biological agent against
R. solani. These results also were confirmed by getting the highest values of vegetative growth parameters (dry weight and stem diameter) and biochemical features (chlorophyll content, chlorophyll fluorescence, and enzymatic antioxidants) of tomato seedlings. These results also agree with the findings of Shalaby et al. [
1], in which applied PBZ at 100 mg L
−1 increased tomato seedling resistance to the early blight disease by increasing the photosynthesis efficiency and stem thickness (
Figure 10). These results agree with those of other studies suggesting that PBZ can support growing cultivated plants under biotic stress by enhancing the antioxidant system in plants [
36,
37]. Differences in the pathogenicity of the tested pathogens may be due to their physiological and biochemical components. It may also be related to the genetic makeup of the host variety and pathogen as far as their interaction.
The mode of action of PBZ to control microbial growth may be back to the inhibition of biosynthesis of ergosterol, which is a compulsory constituent of the fungal membrane. In addition, PBZ may have a fungicidal effect since it belongs to the triazole chemical group, besides the inhibition of gibberellin’s biosynthesis with four enantiomers within the PBZ [
38]. Additionally, morphological changes might occur in the tomato seedlings [
1], such as smaller stomatal pores, thicker leaves, and increased number and size of surface appendages on leaves, which may inhibit the penetration of fungal pathogens. Even so, these mechanical barriers can be overcome by the pathogen owing to the fungistatic effect of PBZ revealed previously; the attack of a pathogen in tomato seedlings tissue might be inhibited. The unique chemical formation of PBZ that allows it to bind to an iron atom in the enzymes crucial for gibberellins biosynthesis in plants could also have the ability to bind to the enzymes necessary for steroids production in fungi as well as those that are responsible for the destruction of abscisic acid in plants [
39]. The fungicidal action of triazoles is usually attributed to their interfering with the biosynthesis of sterols, which are necessary components of fungus cell membranes [
39]. Paclobutrazol is not only a PGR but also a fungicide [
40]. This may be the reason why the effect of PBZ on fungal community diversity in the soil.
Concerning the second question: To what extent can applying PBZ improve the resistance of infected tomato seedlings with
R. solani when co-apply with the bioagent of
Trichoderma? The answer should focus on the justification for selecting
R. solani, PBZ, and
Trichoderma in the current study. Firstly, the fungal pathogen of
R. solani was selected to be investigated in the present study due to its ability to cause serious damage to tomato seedlings.
T. harzianum, as a biocontrol agent, was selected among many
Trichoderma species because this species did not influence by applied doses of PBZ but inhibited the mycelium growth of
R. solani. The protective action of
Trichoderma may go back to its role in mediating the signal pathways of ethylene/jasmonate and salicylic acid [
41] or through producing many secondary metabolites [
42,
43,
44]. Secondly, the protective and promotive role of
Trichoderma spp. on plants against soil-borne fungal pathogens (mainly
R. solani) has been confirmed by many researchers depending on plant and
Trichoderma species such as
T. harzianum on common beans [
45],
T. harzianum on radish [
46], and
T. atrobrunneum on tomato [
4]. Thirdly, the effective role of
Trichoderma spp. in managing tomato growing under stress was also reported, including abiotic stress like water deficit stress [
47] or biotic stress [
4]. To our knowledge, there is no publication on the combined impact of PBZ and
T. harzianum on tomato seedlings under the biotic stress of
R. solani. Fourthly, the integrated plant protection strategy using PBZ and
T. harzianum was established to be investigated in the current study. Although many micro-organisms like
Pseudomonas putida was applied to manage the degradation of PBZ and plant growth promotion [
48], the correlation between PBZ and
T. harzianum on tomato seedling infected by
R. solani is still unknown, and further studies are needed.
Is the suggested integrated chemical/biological control an effective managing tool of the root rot disease caused by
R. solani? The terrible damage has been noticed on the infected tomato seedlings with
R. solani without any applied treatment, and this impact may result from spreading of disease, and generating reactive oxygen species [
49]. In the present work,
R. solani has the highest pathogenicity (68%), disease severity (85–90%), and electrolyte leakage (85%) compared to the other studied pathogens on tomato seedlings or without applying different treatments. On the other hand, seedlings infected by
R. solani recorded the lowest values of vegetative growth parameters, chlorophyll fluorescence and its content, and total antioxidants compared to all other treatments.
Different applied doses of PBZ can reduce the infection problems of tomato seedling with
R. solani by supporting the plant growth with stopping the mycelium growth of
R. solani (up to 80%) and make stems stronger against pathogens, as reported by Shalaby et al. [
1]. This mode of action of PBZ was enhanced by co-applying of
Trichoderma in our study. The co-enhanced effect of PBZ in combined with
Trichoderma against R.
solani in the current study maybe has the same trend as anti-fungal treatment when sulfur and
T. harzianum are co-applied against the pathogen
Alternaria porri, which cause the purple blotch disease in onion [
17]. The supporting action of
T. harzianum in both studies was enhanced the growth of seedlings directly and/or indirectly in presence of sulphur and PBZ for onion and tomato, respectively through making plant stronger against diseases.
Taken together these suggested results, there is an association between PBZ and
Trichoderma on infected tomato seedling with
R. solani. It is suggested that co-applying PBZ and
Trichoderma enhanced the tomato resistance to
R. solani by improving the vegetative growth of seedlings, their uptake of nutrients, antioxidant system, chlorophyll system by recording the highest recorded values comparing with other treatments. The reducing mycelium growth in in vitro was stopped the growth up to nearly 60 and 80% when
Trichoderma or PBZ applied alone, whereas the combined application of both stopped this growth 90–100%, and
Trichoderma supported the over-growth on
R. solani when co-applied with PBZ to infected seedlings (
Table 4 and
Table 5), and the suggested reason for the previous impact of PBZ and
Trichoderma may back to the effective bio-agent of PBZ as a suppressive agent [
7,
48], and role of
Trichoderma in producing many secondary metabolites having remarkable biological activities [
43,
50]. More investigations are needed for more detail concerning this association between PBZ and
Trichoderma under infection with
R. solani and other pathogens in open field and protected cultivation.
The images of SEM instrument may confirm the previous results in this study, where using PBZ was showed twisting, shrinking, and collapsing of lysis and hyphae in cultures of
R. solani. Regarding
T. harzianum, the effective bio-agent of
T. harzianum and suppressive agent of PBZ were noticed, which showed regular hyphal and extensively growth of
Trichoderma in both cases (absent and applied 100 ppm of PBZ), although slightly irregular shape, slightly decreased in spores’ number and its clusters were resulted after applying PBZ on
T. harzianum. This result may agree with what was reported by Shalaby et al. [
1] and Dutta et al. [
51], who confirmed the role of PBZ in ameliorating biotic stress (like
Alternaria solani as a blight disease) on tomato seedlings.